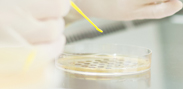

新聞資訊
您當前(qián)的位置:首頁 > 新(xīn)聞資訊
-
綜合(hé)藥品光穩定性試驗箱——為藥品穩定(dìng)性提供適用方案
綜合藥品光穩定性(xìng)試驗箱通常是進行藥品穩定性試驗和持續穩定性考察(chá)兩方麵研究的箱(xiāng)體(tǐ)。藥品穩定性試驗是對藥品穩定性(xìng)的探索性研究...
詳細 -
貝茵新品亮(liàng)相慕尼黑上海分(fèn)析生化展(zhǎn)analytica China
2023年7月(yuè)11日-13日,慕尼黑上海分析生化展(analytica China)在國(guó)家會展中心(上(shàng)海)盛大(dà)舉辦。作(zuò)為實驗室行業盛會,吸引了來(lái)...
詳細 -
BEC係列-半導體製冷低溫培養箱新品首發
...
詳細 -
倒(dǎo)計時一周 一恒(héng)儀器與您相約第十一屆慕尼黑上海分析生化展(zhǎn)analytica China 2023
第十一屆慕尼黑上海分析生化展(analytica China )即將於2023年7月11-13日在國家(jiā)會展中心(上海)8.2H、1.2H、2.2H拉開帷幕,本...
詳細 -
細胞培養的being之旅
細(xì)胞是生(shēng)物學領域研究的重要材(cái)料,而細胞(bāo)培養是指在(zài)體外提供穩定的(de)培養環境(jìng)使細胞健康生長、穩定繁殖的方法。細胞的培養(yǎng)流程並不...
詳細 -
精彩定格 一恒儀器(qì)參展CPHI & PMEC China 2023
為期三天的第二十一屆世界製藥原料中國展(zhǎn)暨第十六屆世界製藥機械、包裝設備與材料中國展(CPHI & PMEC China)於2023年6月21...
詳細

